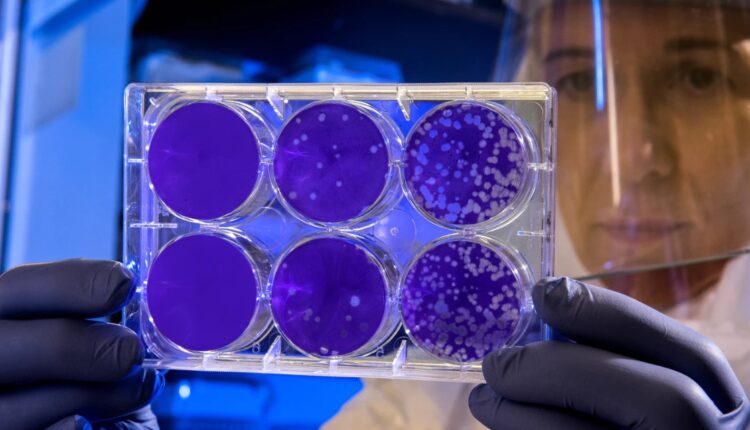

Οι υπουργοί Υγείας της Ομάδας των Επτά πιο ανεπτυγμένων βιομηχανικών χωρών (G7) θα συζητήσουν σήμερα σε τηλεδιάσκεψη για την αντιμετώπιση του νέου κοροναϊού.
Η τηλεδιάσκεψη των υπουργών Υγείας της G7 για τον κοροναϊό έχει προγραμματιστεί να γίνει στις 16:00 ώρα Ελλάδος, διευκρίνισε το υπουργείο Υγείας της Ιταλίας. Η G7 απαρτίζεται από τις ΗΠΑ, τον Καναδά, τη Γαλλία, τη Βρετανία, τη Γερμανία, την Ιαπωνία και την Ιταλία.
Χθες, Κυριακή, ο υπουργός Υγείας της Γερμανίας Γενς Σπαν δήλωσε επίσης ότι οι χώρες της G7 προγραμμάτιζαν την τηλεδιάσκεψη αυτή για να συζητήσουν την αντιμετώπιση με ενιαίο τρόπο του νέου κοροναϊού που εμφανίστηκε στην Κίνα, καθώς, όπως σημείωσε, «δεν έχει νόημα εάν μια χώρα παίρνει μέτρα μόνη της».
Ο αριθμός των θανάτων στην Κίνα από τον νέο κοροναϊό, ο οποίος εμφανίστηκε τον Δεκέμβριο στην πόλη Ουχάν της επαρχίας Χουμπέι στο κεντρικό τμήμα της χώρας, αυξήθηκε σε 361 χθες Κυριακή, με την προσθήκη 57 νέων θανάτων από την προηγούμενη ημέρα.
Την ίδια ώρα η Μαλαισία ανακοίνωσε ότι απέστειλε σήμερα πτήση της AirAsia στην Ουχάν για να φέρει πίσω 141 ανθρώπους και να παραδώσει επίσης 500.000 ζεύγη γαντιών στην Κίνα που πλήττεται από το ξέσπασμα του νέου κοροναϊού,
Όλοι οι επιβαίνοντες, συμπεριλαμβανομένων των 12 μελών του πληρώματος και 14 κυβερνητικών αξιωματούχων της Μαλαισίας, θα υποβληθούν σε ιατρικό έλεγχο μόλις επιστρέψουν και αυτοί που δεν θα παρουσιάζουν συμπτώματα θα σταλούν σε κέντρο παρακολούθησης για 14 ημέρες. Οι άνθρωποι που θα παρουσιάζουν συμπτώματα θα εισάγονται αμέσως στο νοσοκομείο, ανακοίνωσε η Εθνική Υπηρεσία Αντιμετώπισης Καταστροφών.
Τα κρούσματα του νέου κοροναϊού στην Μαλαισία παραμένουν οκτώ και πρόκειται σε όλες τις περιπτώσεις για Κινέζους πολίτες που επισκέπτονταν τη χώρα, ανακοίνωσε παράλληλα σήμερα η κυβέρνηση.
Η Μαλαισία είναι ο μεγαλύτερος παραγωγός στον κόσμο γαντιών και οι εταιρείες της όπως η Top Glove Corp έχουν αυξήσει την παραγωγή για να ανταποκριθούν στην αύξηση της ζήτησης από την ηπειρωτική Κίνα, το Χονγκ Κονγκ και την Ταϊβάν. Η βιομηχανία αυτή της Μαλαισίας έχει επίσης δεσμευτεί να κάνει δωρεά γαντιών στην Κίνα.